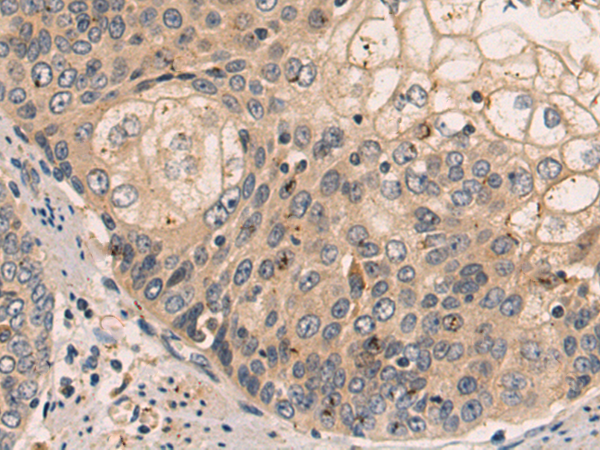
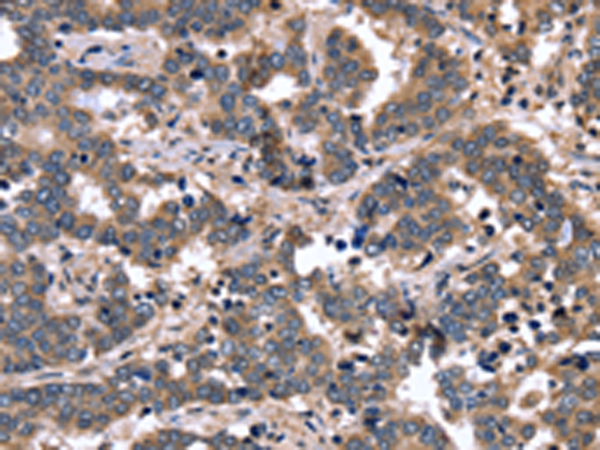
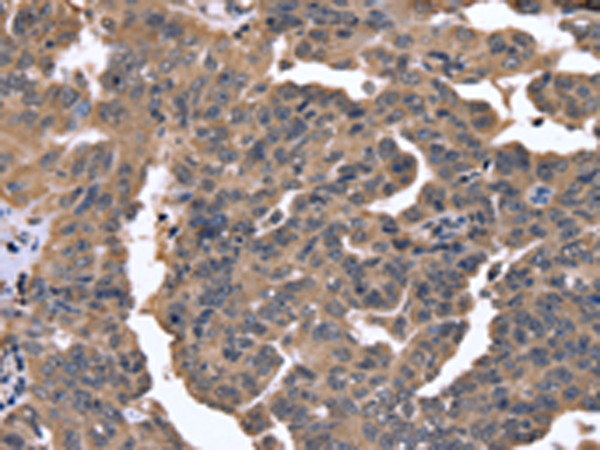
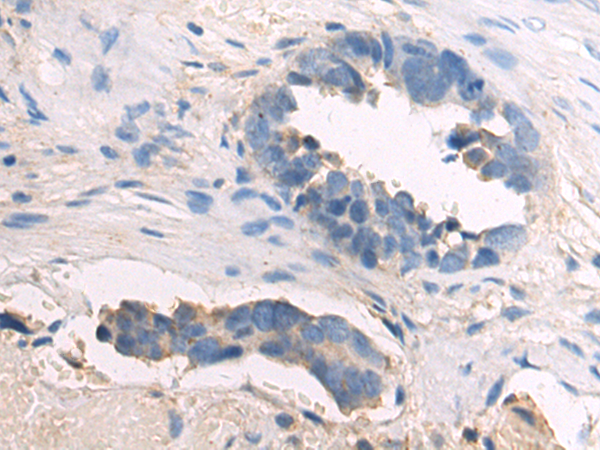

-
分类: 科研抗体货号: P08334别名: KYOT; SLIM; FHL-1; FHL1A; FHL1B; FLH1A; SLIM1; XMPMA; SLIM-1; SLIMMER应用: WB,IHC反应种属: Human, Mouse, Rat
-
分类: 科研抗体货号: P08332别名: T49; pT49应用: WB,IHC反应种属: Human, Mouse
-
分类: 科研抗体货号: P08330别名: WIT3.0; HSPC123-like应用: IHC反应种属: Human, Mouse, Rat
-
分类: 科研抗体货号: P08354别名: 87U6; ARCND1应用: IHC反应种属: Human, Mouse, Rat
-
分类: 科研抗体货号: P08329别名: FOP应用: WB,IHC反应种属: Human, Mouse
-
分类: 科研抗体货号: P08352别名: MYD118; GADD45BETA应用: IHC反应种属: Human, Mouse
-
分类: 科研抗体货号: P08328别名:应用: IHC反应种属: Human, Mouse
-
分类: 科研抗体货号: P08350别名:应用: WB,IHC反应种属: Human, Mouse, Rat
-
分类: 科研抗体货号: P08327别名: ZFGF5; FGF-18应用: WB,IHC反应种属: Human, Mouse, Rat
-
分类: 科研抗体货号: P08349别名: MCL; LRCC; HLRCC; MCUL1应用: WB,IHC反应种属: Human, Mouse, Rat

鄂公网安备42018502007531号
鄂公网安备42018502007531号

